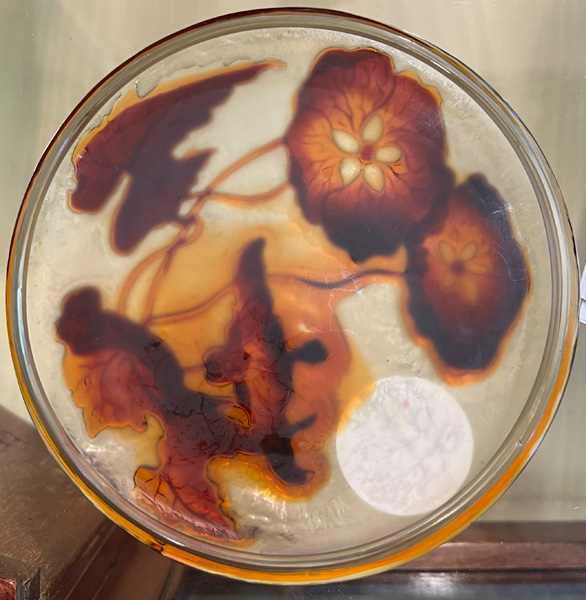

- Katalog-Nr: 40Jugendstil-Deckeldose. Nancy, Émile Gallé um 1900. Farbloses Glas, farbig überfangen, floral geschnitten, teilw. geätzt und feuerpoliert; auf der Wandung sign., H=6,7 cm, D=17 cm.Orientierungswert: € 2.000,-NO RESERVEo.L.Bitte melden sie sich an, um ein elektronisches Vorgebot abzugeben
Zum Anmelden bitte hier klicken
Falls sie sich noch nicht registriert haben, dann klicken sie bitte hier.
Ansonsten können sie das Vorgebot auch gerne wie gehabt mit dem PDF-Vorgebotsformular abgeben.
Vorgebot für diese Katalog-Nr. abgeben
Lot
juvi
2021-06-11T08:26:25+00:00